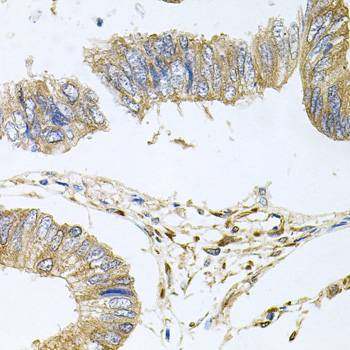
Anti-STRN3 Antibody

Immunohistochemical staining of human small intestine shows strong cytoplasmic positivity in glandular cells.
Anti-STRN3 Antibody
HPA003392
ApplicationsWestern Blot, ImmunoCytoChemistry, ImmunoHistoChemistry
Product group Antibodies
ReactivityHuman
TargetSTRN3
Overview
- SupplierAtlas Antibodies
- Product NameAnti-STRN3 Antibody
- Delivery Days Customer4
- ApplicationsWestern Blot, ImmunoCytoChemistry, ImmunoHistoChemistry
- CertificationResearch Use Only
- ClonalityPolyclonal
- ConjugateUnconjugated
- Gene ID29966
- Target nameSTRN3
- Target descriptionstriatin 3
- Target synonymsPPP2R6B, S/G2NA, SG2NA, striatin-3, cell cycle S/G2 nuclear autoantigen, cell cycle autoantigen SG2NA, nuclear autoantigen, protein phosphatase 2 regulatory subunit B'''beta, s/G2 antigen, striatin, calmodulin binding protein 3
- HostRabbit
- IsotypeIgG
- Protein IDQ13033
- Protein NameStriatin-3
- Scientific DescriptionRecombinant Protein Epitope Signature Tag (PrEST) antigen sequence
- ReactivityHuman
- Storage Instruction-20°C,2°C to 8°C
- UNSPSC41116161